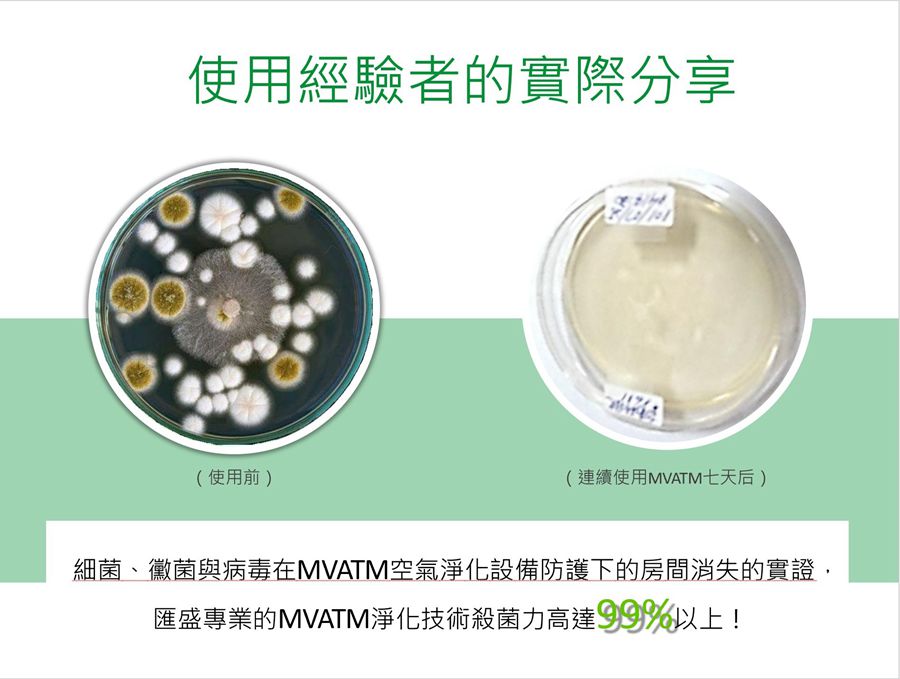

商品說明:
產品規格(操作)
*無耗材 (平日不須刻意維護,僅需撢掉機構外部附著灰塵即可)
*低功耗(僅18W) 全開每月耗電不到 NT$36
*長時間使用,讓安全的淨化因子充滿整個室內空間,效果最佳.
*可以破壞揮發性有機化合物和顆粒物質,包括病毒、細菌和黴菌
*淨化附著於牆面的三手菸、廚房油煙和寵物異味
*全球最輕薄短小的醫療等級主動式空氣淨化器
*強者降臨!30m立方實測報告(一般空氣淨化器僅1.8m立方測試)
*食品加工業也適用
*鍾南山醫療團隊認定

一般常見問題:

MVATM 原理:


輕鬆應對污染物:

權威檢驗報告及專利:







FB粉專:
https://www.facebook.com/MVATMTOP1/?modal=admin_todo_tour
(國家級院士鍾南山專業推薦--健康呼吸,美好人生!)

(產品目徵召為武漢醫療團隊使用,共同為對抗新型肺炎病毒而努力!)
居家辦公院所的防護神器:








附件(檢測報告):
















MVATM 清潔保養就是這麼簡單!
*無耗材!無耗材!無耗材! (因為很重要,所以要說三次)
*清潔保養就是這麼的簡單!
(機器採用MVATM-inside的淨化技術, 具備粒子沉降效果,主要是利用光水離子化反應產生的淨化因子主動撞擊空氣中粒子污染物,使其結合成大粒子,一旦重力大於浮力,污染物就會垂直落入地面、桌面.簡單清掃即可.)😁😁😁



https://www.facebook.com/MVATMTOP1/videos/1114830618859344/?modal=admin_todo_tour
MVATM inside 協助防疫
(協助防疫團隊施作負壓隔離)
(協助防疫)
團隊院士建議:

防疫花絮:






客戶使用回饋:(寵康動物醫院)
客戶使用回饋:(一位好爸爸,使用我們商品,預防小朋友院內感染發生)

MVATM 新聞:
https://read01.com/zh-tw/DG4ydO8.html#.XnjFfogzYRk
ttps://kknews.cc/zh-tw/home/6ornk4q.html
https://smarthome.ofweek.com/2018-07/ART-91009-8300-30248752.html
MVATM inside應用層面:








惟有主動式空氣淨化器(MVATM inside)可以協助你,主動殲滅病毒,築起區域防護網!

愛用客戶自拍抖音宣傳:













 趣買資訊
趣買資訊
